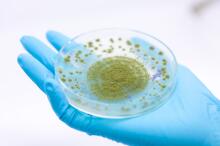

三唑类药物是目前侵袭性曲霉病(IA)的一线药物,在 IA 治疗中发挥重要作用。但其耐药也逐年增加,成为令人担忧的临床问题。2019年4月,发表于《Clin Infect Dis》的一项多中心回顾性队列研究,考察了侵袭性曲霉病的伏立康唑耐药性和死亡率。
背景:三唑耐药性是IA中日益严重的问题。小样本病例系列研究显示,对三唑耐药的感染患者的死亡率为50%~100%,但尚缺乏与三唑敏感IA患者的直接比较。
方法:进行了一项为期5年的回顾性队列研究(2011~2015年),比较了伏立康唑敏感性和伏立康唑耐药性IA患者的死亡率。调查烟曲霉培养阳性的患者,以鉴定患有经证实的、可能的和推定的IA患者。研究人员调查了临床特征、42天和90天死亡率、三唑耐药性特征和抗真菌治疗。
结果:196例IA患者中,37例(19%)伏立康唑耐药。103例(53%)患者患有血液学恶性肿瘤基础疾病,154例(79%)患者开始接受伏立康唑治疗。与伏立康唑敏感病例相比,伏立康唑耐药病例的42天总死亡率增加21%(49% vs 28%;P=0.017),90天总死亡率增加25%(62% vs 37%;P=0.0038)。在非重症监护病房的患者中,伏立康唑耐药患者的42天生存率降低19%(P=0.045)。尽管中位10天后转换为适当的抗真菌治疗,接受合理适当初始伏立康唑治疗患者的死亡率为24%,而接受不当初始伏立康唑治疗患者的死亡率为47%(P=0.016)。
结论:伏立康唑耐药导致IA患者42天总死亡率增加21%,90天总死亡率增加25%。延迟开始合理适当的抗真菌治疗也会增加总死亡率。
(选题审校:王冠儒 编辑:余霞霞)
(本文由北京大学第三医院药剂科翟所迪教授及其团队选题并审校,环球医学资讯编辑完成。)
免责声明
版权所有©北京诺默斯坦管理咨询有限公司。 本内容由环球医学独立编写,其观点并不反映优医迈或默沙东观点,此服务由优医迈与环球医学共同提供。
如需转载,请前往用户反馈页面提交说明:https://www.uemeds.cn/personal/feedback
Clin Infect Dis. 2019 Apr 24;68(9):1463-1471
Voriconazole Resistance and Mortality in Invasive Aspergillosis: A Multicenter Retrospective Cohort Study








 Copyright © 2025 Merck & Co., Inc., Rahway, NJ, USA and its affiliates. All rights reserved.
Copyright © 2025 Merck & Co., Inc., Rahway, NJ, USA and its affiliates. All rights reserved.